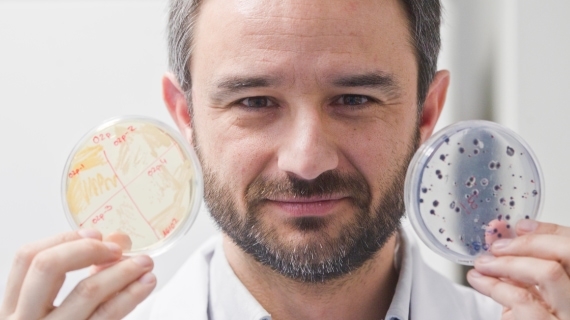

Alex Mira
Oral Microbiome: How to promote symbiosis and prevent dysbiosi
- Doctor in microbiology at Oxford University (UK) with post-doctoral research in the USA and Sweden
- Returnes to Spain in 2003 with the Ramón y Cajal repatriation program and initiates his own research group working on the genomics and metagenomics of oral bacteria
- Awarded with the “Jaime Ferran” National Award for Research in Microbiology and the FIPSE National Award for Health Innovation, the latter for the discovery of S. dentisani and its development as a probiotic to promote oral health
- He is currently the principal investigator of the Oral Microbiome Laboratory at the FISABIO Foundation in Spain, where he has applied metagenomics to the study of dental caries, periodontitis and halitosis
- His current research lines include the study of oral bacteria involved in cardiovascular health and the links between oral microbiota and cancer
Nationality: Spain
Scientific areas: Innovations in dentistry
19 of november, from 11h30 until 12h40
Auditorium D
Conference summary
The latest DNA and RNA analysis technologies have revolutionized the study of microorganisms that live together with human beings, generally known as the microbiome. In our group, we have applied high-throughput sequencing techniques, proteomics and metabolomics to study microbiological communities in the oral cavity, both under health and disease conditions.
These data have allowed us to determine the causing agents of complex diseases such as tooth decay or gum disease, concluding that oral diseases are polymicrobial and the outcome of a microbial dysbiosis.
These oral microbiome studies predict that a caries vaccine may never be efficient and suggest that strategies to promote oral health must be directed towards re-balancing the oral ecosystem, for instance through the use of prebiotics and probiotics. One example has been provided by the comparative study of patients with or without dental caries, which revealed a high frequency of a new Streptococcus species in caries-free individuals, subsequently isolated and baptized as S. dentisani, which inhibits caries-causing bacteria and reduces caries risk.
A second example is given by oral bacteria that convert nitrate from fruits and vegetables into nitrite and nitric oxide, a process which lowers blood pressure due to its vasodilator properties, and also prevents dysbiosis by pH buffering and through the inhibition of pathogens. This suggests the use of nitrate-rich vegetable extracts as oral prebiotics. The clinical implications of these microbiome studies will be discussed.